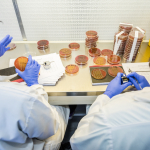
IG635467.jpg

Fortune images: Soweto VIDA Research Institute and Desmond Tutu HIV Foundation

IG635467.jpg
Medical scientists, Christian Mukendi and Nwabisa Jafta count bacterial cells at the WITS VIDA Research Unit lab, located on the grounds of the Chris Hani Baragwanath Academic Hospital in Soweto, South Africa, on November 30, 2022. ©Gates Archive/Ilan Godfrey
Credit information is available in the caption of each photo.
Media assets are intended for use by journalists and foundation partners only.
Please access by creating an Isebox account or logging in via your social media channel of choice. Doing so simply ensures screening of our legal use policy and helps us to keep track of media placements.
If you have any questions, please contact media@gatesfoundation.org.